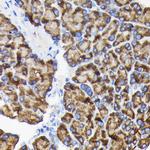
RPS3 Antibody in Immunohistochemistry (Paraffin) (IHC (P))

Search
Invitrogen
RPS3 Polyclonal Antibody
{{$productOrderCtrl.translations['antibody.pdp.commerceCard.promotion.promotions']}}
{{$productOrderCtrl.translations['antibody.pdp.commerceCard.promotion.viewpromo']}}
{{$productOrderCtrl.translations['antibody.pdp.commerceCard.promotion.promocode']}}: {{promo.promoCode}} {{promo.promoTitle}} {{promo.promoDescription}}. {{$productOrderCtrl.translations['antibody.pdp.commerceCard.promotion.learnmore']}}
产品信息
PA5-96153
宿主/亚型
分类
类型
抗原
偶联物
形式
浓度
规格
保存条件
运输条件
RRID
产品详细信息
Immunogen sequence: MAVQISKKRK FVADGIFKAE LNEFLTRELA EDGYSGVEVR VTPTRTEIII LATRTQNVLG EKGRRIRELT AVVQKRFGFP EGSVELYAEK VATRGLCAIA QAESLRYKLL GGLAVRRACY GVLRFIMESG AKGCEVVVSG KLRGQRAKSM KFVDGLMIHS GDPVNYYVDT AVRHVLLRQG VLGIKVKIML PWDPTGKIGP KKPLPDHVSI VEPKDEILPT TPISEQKGGK PEPPAMPQPV PTA; Positive Samples: CEM, MCF-7, SW620, HT-29, Mouse liver, Mouse brain, Mouse heart; Cellular Location: Cytoplasm, Mitochondrion inner membrane, Nucleus, Peripheral membrane protein, cytoskeleton, nucleolus, spindle
靶标信息
WD repeat domain 5 (WDR5) is a member of the WD repeat protein family, which is involved in a variety of cellular processes, including cell cycle progression, signal transduction, apoptosis, and gene regulation. WDR5, also known as BIG-3, is expressed in the developing growth plate, accelerates chondrocyte and osteoblast differentiation in vitro, and regulates osteoblast differentiation during embryonic bone development. WDR5 interacts with the pluripotency factor Oct4/POU5F1 and is required for the efficient formation of induced pluripotent stem (iPS) cells.
仅用于科研。不用于诊断过程。未经明确授权不得转售。